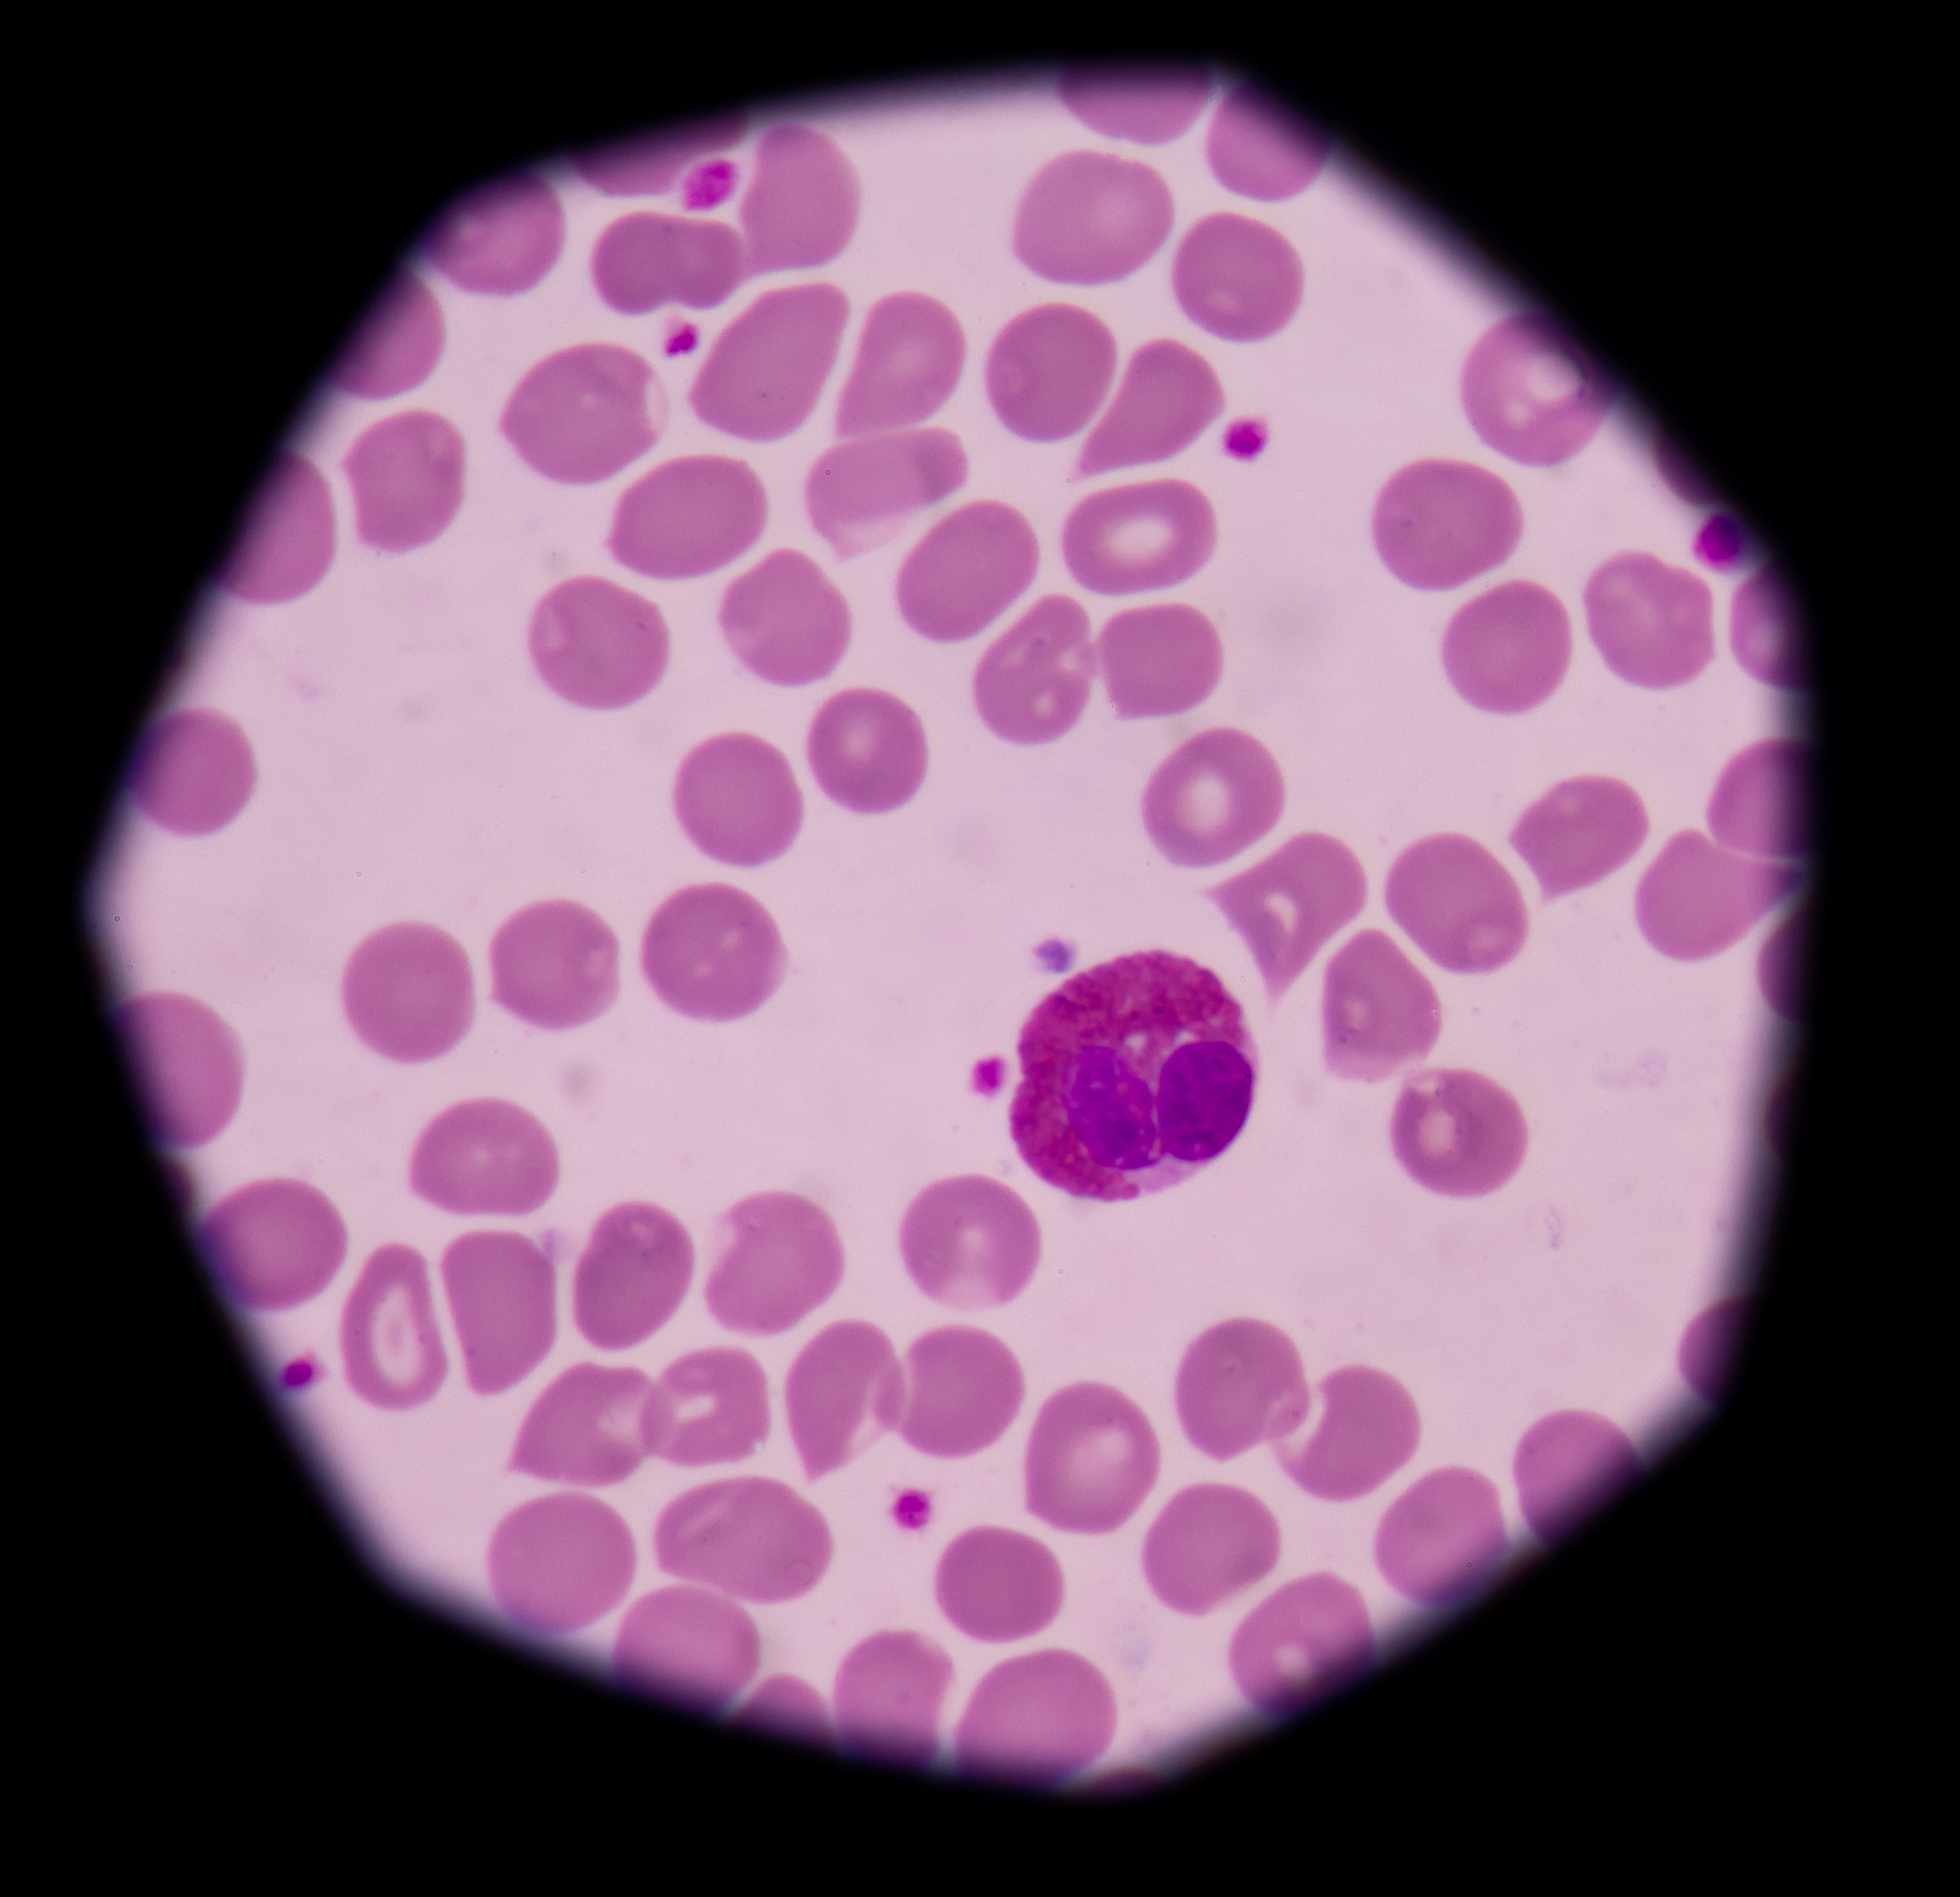
白细胞五分类：中性粒细胞、淋巴细胞、单核细胞、嗜酸性细胞、嗜碱性细胞

白细胞五分类:中性粒细胞、淋巴细胞、单核细胞、嗜酸性细胞、嗜碱性细胞
正确。白细胞五分类是将白细胞按照形态和功能特点分为五类,包括中性粒细胞、淋巴细胞、单核细胞、嗜酸性细胞和嗜碱性细胞。这个分类方法在临床上常用于白细胞计数和分类。

原文地址: https://www.cveoy.top/t/topic/l1eR 著作权归作者所有。请勿转载和采集!
安全问答是一个知识全球问答,包含丰富的问答知识
正确。白细胞五分类是将白细胞按照形态和功能特点分为五类,包括中性粒细胞、淋巴细胞、单核细胞、嗜酸性细胞和嗜碱性细胞。这个分类方法在临床上常用于白细胞计数和分类。
原文地址: https://www.cveoy.top/t/topic/l1eR 著作权归作者所有。请勿转载和采集!